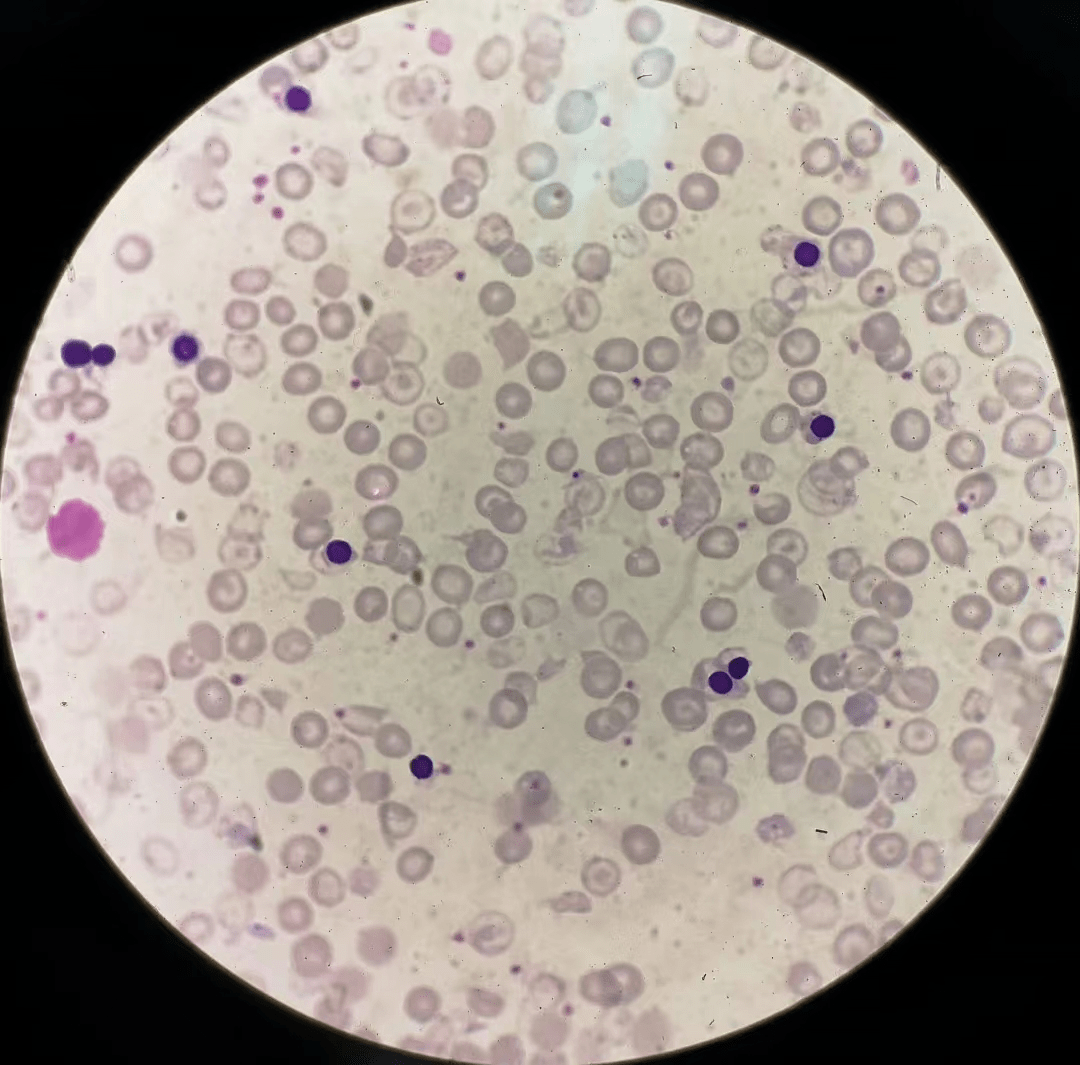
(地贫患者外周血涂片)血涂片镜检可见有核红细胞和网织红细胞增多;红
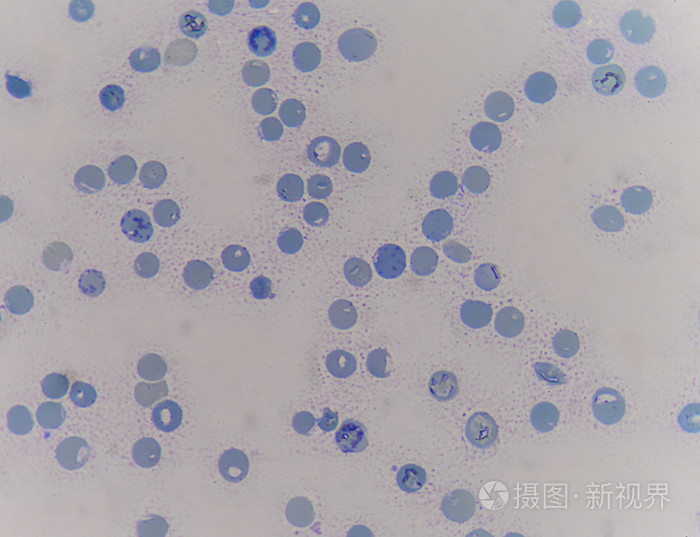
网织红细胞

网织红细胞图片

网织红细胞
图片尺寸1130x878
网织红细胞
图片尺寸960x1279
血涂片上的网状红细胞.
图片尺寸1161x1100
各型网织红细胞_实验诊断学
图片尺寸756x572
其它 周二日常美图 写美篇答案:网织红细胞(点状,破网状) 形态特征
图片尺寸1745x1775
红细胞聚集导致的仪器法网织红细胞计数偏差一例_医学界-助力医生临床
图片尺寸705x617
学术专题丨浅谈网织红细胞量值溯源67
图片尺寸948x648
网织红细胞图片
图片尺寸317x300
网织红细胞计数
图片尺寸1080x1437
网织红细胞
图片尺寸1200x909
红细胞聚集导致的仪器法网织红细胞计数偏差一例_医学界-助力医生临床
图片尺寸789x551
一网织红细胞ret计数
图片尺寸920x690
网织红细胞
图片尺寸1200x909
说说"网织红细胞"与血液病!
图片尺寸387x253
(地贫患者外周血涂片)血涂片镜检可见有核红细胞和网织红细胞增多;红
图片尺寸1080x1065
网织红细胞!#显微镜下的世界 #一分钟干货教学 #每天持 - 抖音
图片尺寸1920x1280
正常红细胞(图片来源网络)
图片尺寸600x600
网织红细胞
图片尺寸700x537
4,网织红细胞降低:解触反射线,药品(抗癌药物,肾上腺生长激素)辐射源
图片尺寸500x487
血液红细胞网织红细胞在血液涂片上照片
图片尺寸317x300